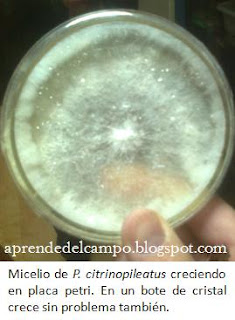

REUTILIZACIÓN DE KITS DE CULTIVO DE HONGOS COMESTIBLES II
Como lo prometido es deuda, en esta ocasión voy a pasar a comentar mis experiencias con la reutilización de kits de cultivo de hongos comestibles con troncos procedentes de restos de poda.
Con la llegada del invierno es común que se lleven a cabo tareas de mantenimiento en el arbolado de zonas urbanas aprovechando el parón vegetativo. Si bien es cierto que es más adecuado esperar a realizar estas tareas cuando ha pasado el periodo de heladas fuerte, desde diciembre hasta principios de marzo no resulta muy complicado encontrar maderas adecuadas para el cultivo de hongos saprófitos (descomponedores de materia orgánica) al pie de los árboles podados o en los apartaderos de residuos orgánicos, en urbanizaciones de la periferia de los núcleos urbanos.
Lo primero de todo es, como no, asegurarse de que el destino de esa madera es el vertedero (para no entrar en conflicto con nadie), y después asegurarse de que se trata de una especie apta; la más recomendable, la de chopo (Populus nigra, Populus x canadensis, o Populus alba principalmente). No debemos coger madera que lleve varios meses cortada porque es muy probable que esté siendo colonizada ya por otro hongo.
Una vez tengamos nuestro leño, escogiéndolo a ser posible entre 20-30 cm de grosor y de un mínimo de 50 cm de longitud, lo guardaremos para su posterior utilización.
Por otro lado, con una pequeña porción de sustrato infectado con el hongo, procedente del kit comercial, cultivaremos el micelio en extracto de malta agar casero (como se explicó en el anterior post), para estimular su crecimiento y aislar al hongo de otros posibles microorganismos que se hubieran instalado en el kit.
 Posteriormente, pondremos a cocer trigo en grano tomando como medida aproximadamente la tercera parte del bote de mermelada vacío que vayamos a usar (al cocer dilata), teniendo cuidado de que los granos queden algo duros, sin llegar a romperse por sí solos. Una vez que se ha alcanzado esta textura, se introduce en el bote de mermelada y se le coloca una tapa con filtro de algodón y se deja al baño maría en olla a presión durante media hora.
Posteriormente, pondremos a cocer trigo en grano tomando como medida aproximadamente la tercera parte del bote de mermelada vacío que vayamos a usar (al cocer dilata), teniendo cuidado de que los granos queden algo duros, sin llegar a romperse por sí solos. Una vez que se ha alcanzado esta textura, se introduce en el bote de mermelada y se le coloca una tapa con filtro de algodón y se deja al baño maría en olla a presión durante media hora.Al día siguiente, con el bote ya a temperatura ambiente, introducimos con la ayuda de unas pinzas esterilizadas a la llama, varias porciones de micelio procedente del bote en el que lo hicimos crecer sobre extracto de malta agar casero, intentando abrir el bote con trigo por el lado contrario a nuestra respiración (para evitar contaminaciones). Para que crezca de una forma más homogénea, se puede agitar el bote cerrado para que las porciones de micelio se distribuyan mejor entre el trigo.
 Tras esto, sólo queda dejar el bote en un lugar oscuro a unos 20ºC de temperatura hasta que todo el bote esté blanco por el crecimiento del hongo. El micelio llega incluso a producir primordios, pero, al menos en mis experiencias, nunca llegan a desarrollarse hasta un tamaño aprovechable.
Tras esto, sólo queda dejar el bote en un lugar oscuro a unos 20ºC de temperatura hasta que todo el bote esté blanco por el crecimiento del hongo. El micelio llega incluso a producir primordios, pero, al menos en mis experiencias, nunca llegan a desarrollarse hasta un tamaño aprovechable.Posteriormente, con la ayuda de un taladro, perforaremos la madera de chopo en varios puntos a una distancia máxima de 20 cm en longitud por al menos 2 lados de la troza seleccionada y a continuación, introduciremos en las perforaciones con cuidado el trigo con micelio utilizando guantes de nitrilo xa ello desinfectados con alcohol al 70%.
Una vez hayamos introducido el trigo infectado, sólo queda tapar con algo que lo contenga allí (parafilm, cinta aislante, film transparente), encerrarlo en una bolsa para evitar pérdidas de humedad, y dejarlo incubar a unos 20ºC en oscuridad.
Transcurridos unos 3 meses, el tronco estará cubierto de micelio blanco en toda su superficie, retiraremos la bolsa y lo llevaremos a un lugar iluminado, sin sol directo, y con una humedad alta (mínimo del 70%). No tardarán en aparecer las primeras setas y, aunque se consigue mucha menor producción que sobre café o paja, se mantiene durante al menos dos temporadas.
¡Espero que haya sido de utilidad y comentéis vuestras experiencias!